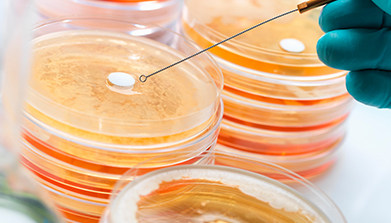
上海它山测检测技术有限公司
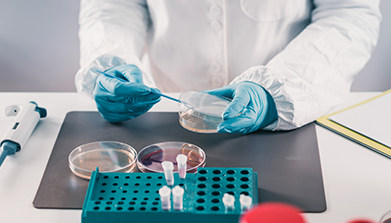
上海它山测检测技术有限公司

选择您需要咨询的行业
CHOOSE INDUSTRY
-


驱避(灭)害虫试验
-


斑马鱼功效检测
-


日化及消毒品
-


病毒灭活试验
-


化妆品功效检测
-


毒理安全性试验
-


医疗器槭
-


药品检测
-


功效评价
-


保健品功效
关于它山
ABOUT US

专业检测公司—用品质见证承诺
上海它山测检测技术有限公司是一家专业从事检测、测试、技术咨询等服务的科创型技术企业,致力于打造国内专业的第三方检测服务机构,为全球范围内的企业及相关机构提供专业、公正、严谨的第三方检验检测及咨询服务。自成立以来,它山检测凭借守信创新、稳步发展,现已拥有一批长期从事检验、检测、咨询服务的技术精英,依托服务开拓市场的经营策略,深挖市场需求;它山检测主要从事杀灭(驱避)蚊虫害虫类检测,斑马鱼功效检测,提供国内外认证服务,化妆品检测,日化消毒产品检测、毒理检测、高校科研等相关检测服务。
-

提供一对一的问题解答和测试追踪
-

严格执行测试流程/收费规范
-

保密性/权威性
-

一站式检测